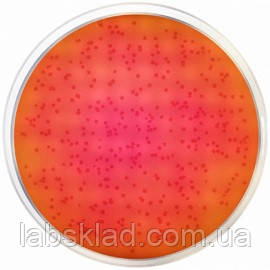
Агар з діамантовим зеленим модифікований (ISO 6579, ISO 19250) Conda 500 г 1143, фото 1

Агар з діамантовим зеленим модифікований (ISO 6579, ISO 19250) Conda 500 г 1143
4 716,49 ₴
- Готово до відправки
- Код: Х0155808
+380 (67) 011-17-74
Менеджер- +380 (48) 704-68-90Офіс, Одесса (агрогалузь)
Характеристики
| Користувальницькі характеристики | |
|---|---|
| Каталожний номер постачальника | 1143 |
Інформація для замовлення
- Ціна: 4 716,49 ₴

